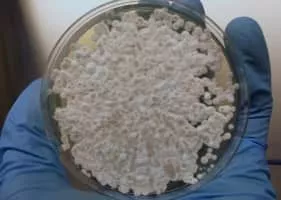

Pseudogymnoascus Destructans
| Use attributes for filter ! | |
| Scientific name | Pseudogymnoascus destructans |
|---|---|
| Phylum | Ascomycota |
| Higher classification | Pseudogymnoascus |
| Rank | Species |
| Date of Reg. | |
| Date of Upd. | |
| ID | 2306834 |
About Pseudogymnoascus Destructans
Pseudogymnoascus destructans is a psychrophilic fungus that causes white-nose syndrome, a fatal disease that has devastated bat populations in parts of the United States and Canada. Unlike species of Geomyces, P. destructans forms asymmetrically curved conidia.